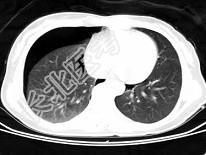

试题详情
- 单项选择题男,35岁, 胸部外伤,CT图像如图, 最可能的诊断为 ( )
A、支气管囊肿并感染
B、畸胎瘤
C、右侧气胸
D、右侧液气胸
E、右侧脓胸
关注下方微信公众号,搜题查看答案

热门试题
- 伤员左胸挤压伤,伤后出现呼吸困难,气管右
- 女性,42岁, 不慎摔倒4小时,诉右侧胸
- 破伤风发病时,最先出现的症状是A、苦笑面
- 病人蛋白质缺乏对手术可能发生的影响有A、
- Tietze病是指 ( )A、非
- 不利于创伤修复最常见的因素是A、感染B、
- 多根多处肋骨骨折伴有反常呼吸时处理原则是
- 对创伤的治疗过程中,应注意了解事项中哪项
- 患者,男性,69岁,食管癌术后五天,胸腔
- 关于食管癌的淋巴转移特点,下列错误的是A
- 导致代谢碱中毒的最常见外科病是A、幽门梗
- 男性,41岁,胸背部多处被刀刺伤。体格检
- 下列哪项不是脓胸致病菌进入胸膜腔的常见途
- 1、开始外科治疗的最佳时机2、最可能的诊
- 1、可能是何种原发疾病引起 (
- 腰椎穿刺部位应选择A、成人L
- 腹腔镜手术常见的并发症有A、腹腔出血B、
- 休克的特殊监测指标包括A、动脉血乳酸盐测
- 进行性血胸的诊断依据不包括A、胸膜腔穿刺
- 中等量出血的血胸患者,早期不应出现A、昏